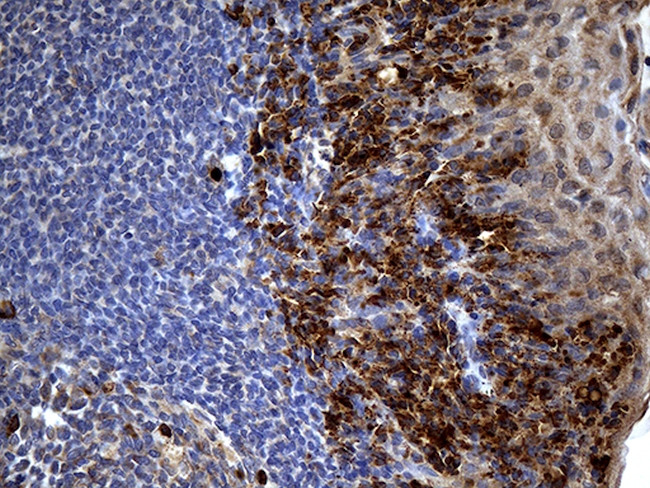
PPP4R4 Antibody in Immunohistochemistry (Paraffin) (IHC (P))

Search
OriGene
PPP4R4 Monoclonal Antibody (OTI1G7), TrueMAB™
{{$productOrderCtrl.translations['antibody.pdp.commerceCard.promotion.promotions']}}
{{$productOrderCtrl.translations['antibody.pdp.commerceCard.promotion.viewpromo']}}
{{$productOrderCtrl.translations['antibody.pdp.commerceCard.promotion.promocode']}}: {{promo.promoCode}} {{promo.promoTitle}} {{promo.promoDescription}}. {{$productOrderCtrl.translations['antibody.pdp.commerceCard.promotion.learnmore']}}
产品信息
TA810585
种属反应
宿主/亚型
分类
类型
克隆号
抗原
偶联物
形式
浓度
纯化类型
保存液
内含物
保存条件
运输条件
靶标信息
The protein encoded by this gene is a HEAT-like repeat-containing protein. The HEAT repeat is a tandemly repeated, 37-47 amino acid long module occurring in a number of cytoplasmic proteins. Arrays of HEAT repeats form a rod-like helical structure and appear to function as protein-protein interaction surfaces. The repeat-containing region of this protein has some similarity to the constant regulatory domain of the protein phosphatase 2A PR65/A subunit. The function of this particular gene product has not been determined. Alternative splicing has been observed for this gene and two transcript variants encoding distinct isoforms have been identified.
仅用于科研。不用于诊断过程。未经明确授权不得转售。
篇参考文献 (0)
生物信息学
蛋白别名: cilia and flagella associated protein 14; HEAT-like repeat-containing protein; protein phosphatase 4, regulatory subunit 4; Serine/threonine-protein phosphatase 4 regulatory subunit 4
基因别名: CFAP14; KIAA1622; PP4R4; PPP4R4
UniProt ID: (Human) Q6NUP7
Entrez Gene ID: (Human) 57718